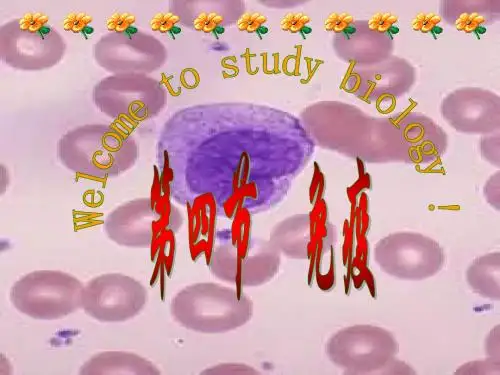

三、特异性免疫:
抗原
概念:能够引起机体产生特异性免疫反应的物质。
举例:细菌、病毒、癌细胞、衰老细移植的器官 特性:异物性、大分子性、特异性
概念:机体受抗原刺激后产生的,能与该抗原发生
特异性结合的具有免疫功能的蛋白质
抗体
特性:特异性
分布:血清、组织液、淋巴
体液免疫: B细胞主要依靠产生抗体来消灭抗原、
有特异性
体液免疫 细胞免疫
四、 免疫失调引起的疾病
1)自身免疫病
免疫功能过高
2)过敏反应 3)免疫缺陷症等 免疫功能过低
五、 免疫学的应用
• 免疫学应用在三个方面: 1.免疫预防(接种疫苗) 2.抗原检测 3.器官移植
1、下列不属于免疫器官的是
A.脾 B.淋巴结 C.扁桃体 D.肝脏
2.属于保卫人体的第二道防线的是 A.皮肤、黏膜 B.T细胞 C.吞噬细胞 D.B细胞
3.关于特异性免疫和非特异性免疫的叙述中,不 正确的是
A、发生非特异性免疫的结构主要是皮肤、黏膜、 吞噬细胞等,发生特异性免疫的结构是机体的免疫 系统
B.非特异性免疫出现早、作用范围广,特异性免 疫出现晚、作用范围小、针对性强
C.特异性免疫是在非特异性免疫的基础上形成的
D.非特异性免疫是在特异性免疫的基础上形成的
12.现有一幼鼠,先天无胸腺,此鼠的免疫状况是 A.有全部的细胞免疫能力 B.丧失一切免疫能力 C.有全部的体液免疫能力 D.保留部分体液免疫能力 13.下列关于细胞免疫的叙述,错误的是 A、进行细胞免疫时,抗原也需经吞噬细胞的处理 B、细胞免疫主要消灭侵入人体细胞内部的抗原 C、效应T细胞可直接杀灭抗原 D、记忆T细胞接受同一种抗原再次刺激时,会迅速增值分化